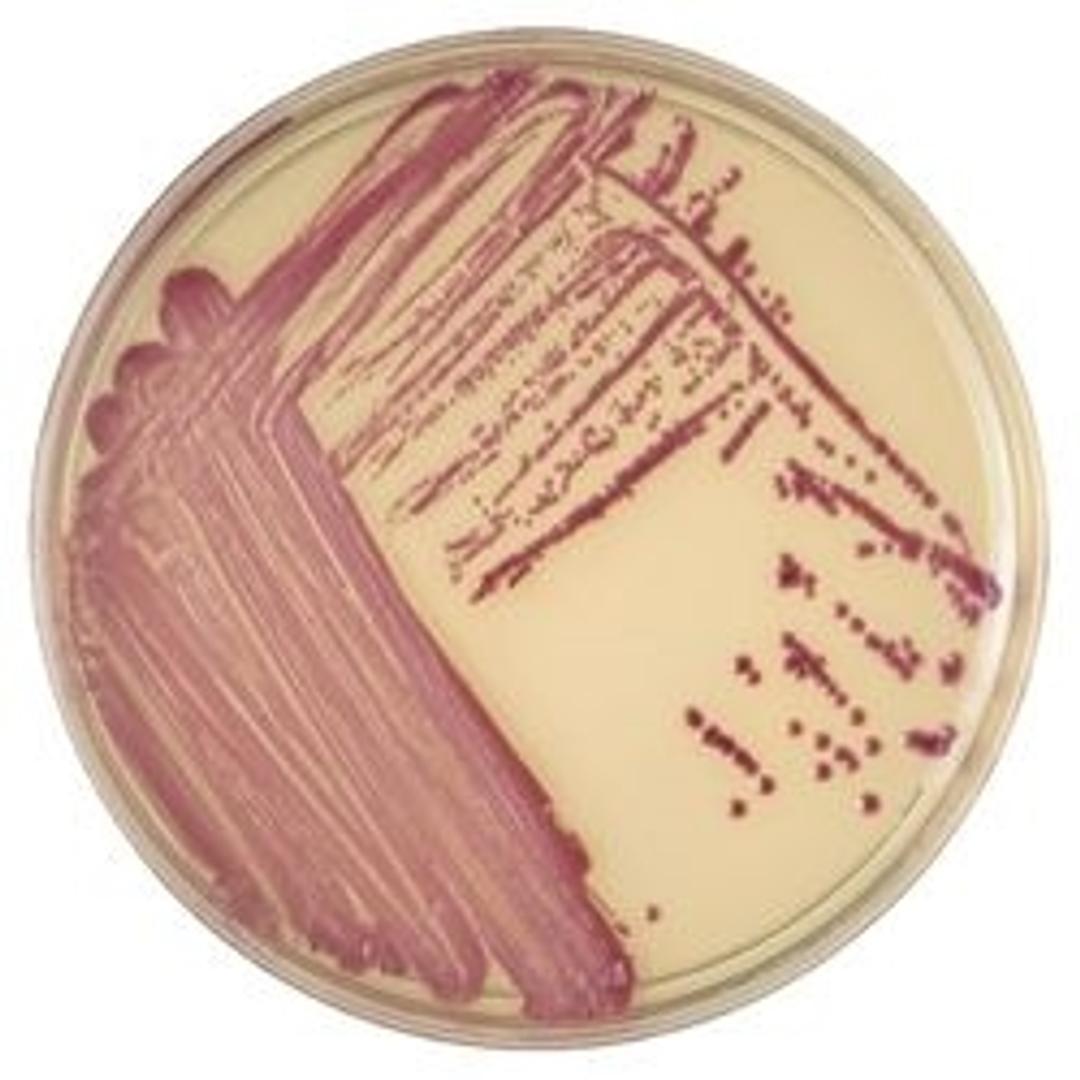
BD BBL™ CHROMagar™ MRSA II Plate

BD BBL™ CHROMagar™ MRSA II Plate
BD BBL™ CHROMagar™ MRSA II is designed for the qualitative, direct detection of nasal colonization by methicillin-resistant Staphylococcus aureus (MRSA).

The supplier does not provide quotations for this product through SelectScience. You can search for similar products in our Product Directory.
The BBL™ CHROMagar™ family of products utilize a chromogen mix that consists of artificial substrates (chromogens) that release differently colored compounds upon degradation by specific microbial enzymes, thus assuring the direct differentiation of certain species or the detection of certain groups of organisms with only a minimum of confirmatory tests.
BD BBL™ CHROMagar™ MRSA II
• A selective and differential medium for the direct detection of methicillin-resistant Staphylococcus aureus (MRSA) from clinical specimens. from a wide range of clinical specimen types
• Final result in 20-26 hrs; fits into any routine laboratory workflow
• No additional confirmatory testing is required
• Directly identify MRSA without confirmatory testing, for auto batch release with the BD Kiestra™ imaging application.
Note: Not all products are available in all geographies, please contact your local BD representative for product details, specs, or ordering information.